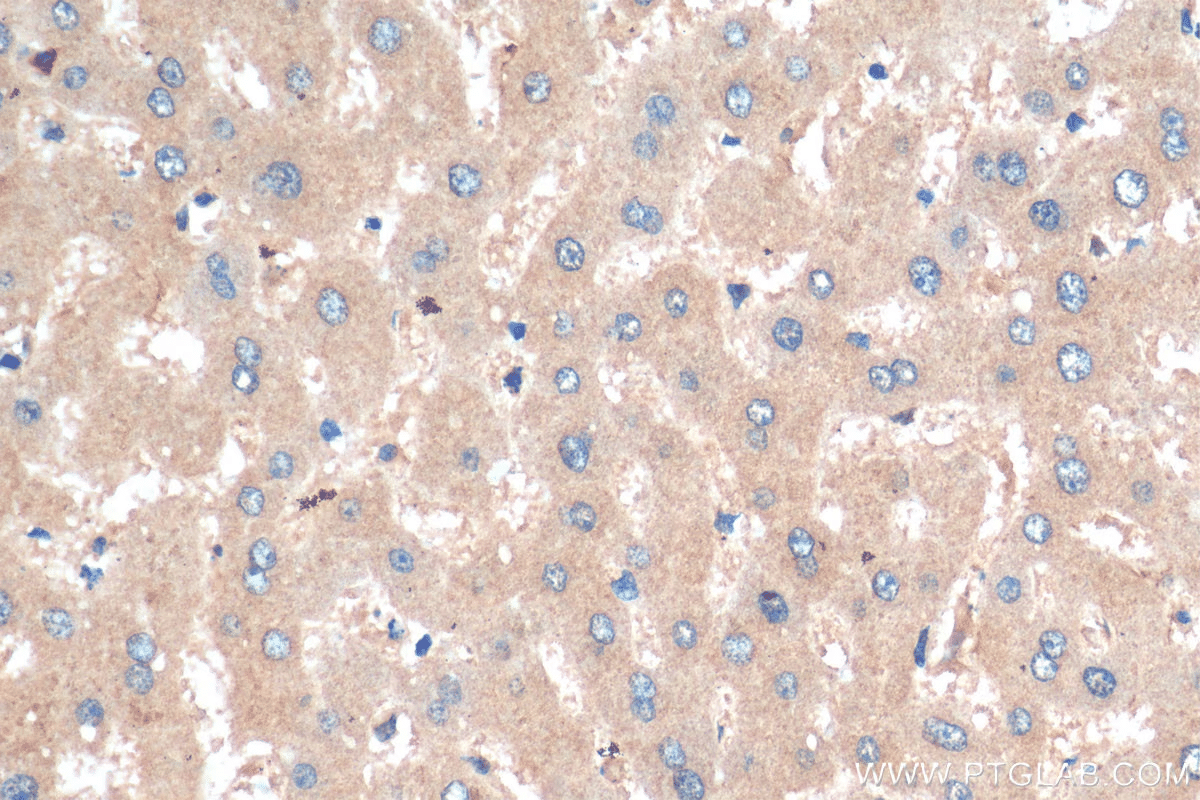
Complete What Is Nuclear Antibody Positive Meaning?b 3 Complete What Is Nuclear Antibody Positive Meaning?b

Getting a positive ANA test result can worry you. But, it’s key to know it doesn’t mean you have an autoimmune disease right away. At Liv Hospital, we aim to educate and support our patients fully.what is nuclear antibody positiveWhat is an ANA Test? Positive Steps After
An ANA test checks for antinuclear antibodies in your blood. These antibodies are proteins your immune system makes to fight off foreign stuff.
If your test comes back positive, it means you have these antibodies. This can hint at autoimmune conditions. Yet, lots of people who are healthy also test positive without getting sick.
Key Takeaways
- A positive ANA test result needs careful thought.
- Antinuclear antibodies are proteins made by your immune system.
- A positive result doesn’t necessarily mean you have an autoimmune disease.
- Many healthy individuals have a positive ANA test without developing illness.
- Comprehensive medical evaluation is key to understanding your test results.
The Basics of Antinuclear Antibodies (ANA)

To understand what a positive ANA test means, we need to know about antinuclear antibodies. These antibodies target the nucleus of our cells. We’ll look into what ANA are and how they affect our bodies.
What Are Antinuclear Antibodies?
Antinuclear antibodies are autoantibodies that attack our own tissues, focusing on the cell nucleus. A test called the ANA test or lupus antinuclear antibody test can find these antibodies. This test is key for diagnosing autoimmune diseases.
The ANA test is not specific to one disease but is used to detect various autoimmune conditions. Some common characteristics of ANA include:
- They are directed against the cell nucleus.
- They can be found in the blood.
- Their presence is associated with autoimmune diseases.
How Antinuclear Antibodies Affect the Body
When ANA are present, they can cause inflammation and damage to various body tissues. The body’s immune system mistakenly attacks healthy cells. This can lead to conditions like Systemic Lupus Erythematosus (SLE), Rheumatoid Arthritis, and other autoimmune diseases.
The effects of ANA on the body can vary widely among individuals. Some people may not experience any symptoms, while others may face significant health issues. The ANA laboratory test helps identify these antibodies. It aids in diagnosing and managing related conditions.
Key points to consider about the impact of ANA include:
- The level of ANA can correlate with disease activity.
- High levels of ANA are often associated with autoimmune diseases.
- The presence of ANA can precede the onset of symptoms.
What Is Nuclear Antibody Positive: Interpreting Test Results
An ANA test positive means your body is making antibodies against its own cells. This shows antinuclear antibodies in your blood. It could mean you have an autoimmune disease, a viral infection, or another health issue.
Definition of a Positive ANA Test
A positive ANA test shows more antinuclear antibodies than normal. It uses an immunofluorescence assay (IFA) to find these antibodies.
Key aspects of a positive ANA test include:
- The titer level, which shows how much ANA is in your blood.
- The pattern of fluorescence seen under a microscope, which hints at the condition.
Common Patterns and Their Significance
There are several ANA fluorescence patterns, each linked to different autoimmune diseases.
Common patterns include:
- Homogeneous pattern: Often linked to Systemic Lupus Erythematosus (SLE).
- Speckled pattern: Seen in various diseases, including SLE and Sjögren’s syndrome.
- Nucleolar pattern: Usually points to scleroderma.
- Centromere pattern: Common in limited systemic scleroderma.
Experts say, “A specific ANA pattern can lead to more tests and help find the autoimmune disease.”
“Understanding ANA test results needs a deep look at the patient’s symptoms and overall health.”
A positive ANA result doesn’t mean you have an autoimmune disease. More tests are needed to find out why the result is positive and what disease it might be.
ANA Titer Explained: Understanding the Numbers
ANA titers show how much antinuclear antibodies are in a patient’s blood. Knowing about ANA titers helps doctors understand test results better. This knowledge is key for taking good care of patients.
How ANA Titers Are Measured
Doctors measure ANA titers by diluting the patient’s blood. They keep diluting until the test is no longer positive. This tells them the titer level, which shows how severe the autoimmune condition is.
“The titer shows how much antibody is in the blood,” says Medical Expert, a top rheumatologist. “A higher titer means more antibodies, which can mean more autoimmune activity.”
What Different Titer Levels Mean
What ANA titer levels mean can change based on the lab and test method. A titer of 1:80 or higher is usually positive. But, this can differ. A positive ANA test at a significant titer means an autoimmune disorder is likely.
- A titer of 1:80 is often low positive and can be seen in healthy people or those with mild autoimmune conditions.
- A titer of 1:320 or higher is usually high and linked to serious autoimmune diseases like Systemic Lupus Erythematosus (SLE).
Clinical Significance of High vs. Low Titers
ANA titers are important for diagnosing and tracking autoimmune diseases. High titers often mean the disease is active. Low titers might show the disease is in remission or in healthy people.
A study in the Journal of Rheumatology found that high ANA titers are a strong sign of autoimmune disease, like SLE. This shows how important it is to look at ANA titers with the patient’s symptoms and other tests.
|
Titer Level |
Clinical Significance |
|---|---|
|
1:80 |
Low positive; may be seen in healthy individuals or mild autoimmune conditions. |
|
1:320 |
High; associated with significant autoimmune diseases like SLE. |
The Prevalence of Positive ANA in Healthy Individuals
It’s important to know how common positive antinuclear antibodies (ANA) are in healthy people. Research shows that 3 to 15 percent of people without autoimmune diseases have ANA.
Statistical Overview
Many healthy adults may test positive for ANA. This is more common in certain groups. For example, many healthy women over 65 may have a positive ANA test.
|
Demographic |
Prevalence of Positive ANA |
|---|---|
|
Healthy Adults |
3-15% |
|
Women over 65 |
Higher prevalence |
Factors Affecting False Positive Results
Some things can cause false positive ANA test results. For example, some medicines can lead to positive tests in healthy people. It’s key to consider these when looking at test results.
Common Factors Leading to False Positives:
- Certain medications
- Age-related changes
- Other non-autoimmune conditions
Knowing these factors helps make better decisions about testing and diagnosis.
Autoimmune Conditions Associated with Positive ANA
Antinuclear antibodies in the blood can signal various autoimmune conditions. A positive ANA test is a key indicator for diagnosing and monitoring autoimmune diseases.
Systemic Lupus Erythematosus (SLE)
Systemic Lupus Erythematosus, or lupus, is a chronic autoimmune disease. It can affect many organs in the body. A positive ANA test is found in about 98% of SLE patients, making it a key diagnostic criterion.
Rheumatoid Arthritis
Rheumatoid arthritis is an autoimmune disorder that mainly affects the joints. It causes inflammation and pain. While not as strongly linked to ANA as SLE, many rheumatoid arthritis patients test positive for ANA, often those with severe disease.
Sjögren’s Syndrome
Sjögren’s syndrome is an autoimmune condition that affects the exocrine glands. It leads to dry mouth and dry eyes. A positive ANA test is common in Sjögren’s syndrome patients.
Scleroderma
Scleroderma, or systemic sclerosis, is an autoimmune disease that affects the skin and connective tissue. It causes fibrosis and hardening of these tissues. Many scleroderma patients test positive for ANA, with specific patterns indicating different subsets of the disease.
The following table summarizes the autoimmune conditions associated with positive ANA test results and their characteristic features:
|
Condition |
Primary Characteristics |
ANA Association |
|---|---|---|
|
Systemic Lupus Erythematosus (SLE) |
Multi-organ inflammation, skin rashes, joint pain |
Highly associated (~98% positive ANA) |
|
Rheumatoid Arthritis |
Joint inflammation, pain, and deformity |
Moderately associated |
|
Sjögren’s Syndrome |
Dry eyes, dry mouth, glandular dysfunction |
Commonly associated |
|
Scleroderma |
Skin thickening, fibrosis, vascular issues |
Frequently associated |
Understanding the link between positive ANA results and these autoimmune conditions is key for accurate diagnosis and effective management. The ANA test is a valuable tool in the diagnostic process. It helps healthcare providers identify patients who may need further evaluation and treatment.
The Relationship Between ANA and Lupus
Lupus and ANA are closely linked, but a positive ANA test doesn’t confirm lupus. Let’s dive into why. The antinuclear antibody (ANA) test is key in diagnosing autoimmune diseases, like Systemic Lupus Erythematosus (SLE).
Why Only 10-13% of Positive Tests Indicate Lupus
Research shows that only 10 to 13 percent of people with a positive ANA test have lupus. This shows how complex ANA test results can be. A positive ANA test is just one clue in diagnosing lupus.
ANA can be linked to many conditions, not just lupus. It’s important to understand the context and other diagnostic criteria.
ANA Patterns Specific to Lupus
Certain ANA patterns are more common in lupus. These include:
- Homogeneous Pattern: Often seen in lupus patients, this pattern indicates antibodies against DNA.
- Peripheral Pattern: Also associated with lupus, this pattern is linked to antibodies against DNA.
- Nucleolar Pattern: While less specific to lupus, it can be seen in some cases.
Identifying these patterns helps doctors narrow down the diagnosis.
Other Diagnostic Criteria for Lupus
Diagnosing lupus requires a mix of clinical evaluation and lab tests. Along with the ANA test, other criteria include:
|
Diagnostic Criteria |
Description |
|---|---|
|
Clinical Manifestations |
Presence of symptoms such as joint pain, skin rashes, and kidney issues. |
|
Anti-dsDNA Antibodies |
High levels are highly specific for lupus. |
|
Complement Levels |
Low complement levels can indicate active lupus. |
When Is an ANA Test Ordered?
Doctors often order an ANA test for patients showing signs of autoimmune diseases. This test checks for antinuclear antibodies, which are linked to many autoimmune conditions.
Common Symptoms Leading to Testing
Some symptoms make doctors think about ordering an ANA test. These include:
- Prolonged fever
- Skin rashes
- Fatigue
- Joint pain and swelling
- Swollen glands
Doctors might suggest an ANA test if patients show these signs. It helps figure out if an autoimmune disease is present.
Risk Factors That Prompt Testing
Some people are more likely to get autoimmune diseases. Doctors might test for ANA if they see these risk factors. These include:
|
Risk Factor |
Description |
|---|---|
|
Family History |
A history of autoimmune diseases in the family |
|
Age and Gender |
Autoimmune diseases are more common in women and can occur at any age |
|
Other Medical Conditions |
Presence of other autoimmune or chronic conditions |
Screening vs. Diagnostic Testing
The ANA test serves both screening and diagnostic purposes. Screening tests are for people without symptoms but with risk factors. Diagnostic testing is for those with symptoms to find the cause.
It’s important to know the difference between screening and diagnostic tests. This helps understand ANA test results better.
The ANA Testing Process
The ANA test is a key tool for diagnosing autoimmune diseases. It’s a simple blood test that looks for antinuclear antibodies. This test helps doctors diagnose and monitor these conditions.
Testing Methods and Techniques
The ANA test uses two main methods: Indirect Immunofluorescence Assay (IFA) and Enzyme-Linked Immunosorbent Assay (ELISA). IFA is the top choice because it’s very sensitive and can find many types of antibodies.
Table: Comparison of ANA Testing Methods
|
Method |
Sensitivity |
Specificity |
Common Use |
|---|---|---|---|
|
IFA |
High |
Moderate |
Initial screening |
|
ELISA |
Moderate |
High |
Confirmatory testing |
Preparing for the Test
Getting ready for an ANA test is easy. You might need to fast for a few hours beforehand. This can change based on the lab’s needs. Also, tell your doctor about any medicines you’re taking, as they might affect the test.
What to Expect During and After
A healthcare professional will take a blood sample from your arm. You might feel a pinch when the needle goes in or comes out. Then, the blood goes to a lab for testing.
The results usually come back in a few days to a week. Your doctor will explain what they mean. A positive result doesn’t always mean you have an autoimmune disease. More tests are needed to figure out what’s going on.
Getting tested can be stressful. But, the ANA test is safe and common. If you’re worried or have questions, talk to your doctor. They can help and support you.
Limitations and Misinterpretations of ANA Testing
It’s important to know the limits of Antinuclear Antibody (ANA) testing for accurate diagnosis. ANA testing is useful in diagnosing autoimmune diseases but has its own set of challenges.
Why a Positive Test Isn’t a Diagnosis
A positive ANA result doesn’t mean you have an autoimmune disease. Alone, ANA test results can’t pinpoint a specific disease. We combine ANA test results with other blood tests and patient health info for a diagnosis.
ANA can be found in healthy people too. A positive result doesn’t always mean you’re sick. For example, many healthy people can have ANA, even at low levels.
Key points to consider:
- A positive ANA test is not a definitive diagnosis.
- ANA can be present in healthy individuals.
- Low titers are more likely to be seen in healthy individuals.
The Importance of Clinical Correlation
When we look at ANA test results, we must consider more than just the test. Healthcare providers look at symptoms, medical history, and other test results. This helps understand the meaning of a positive or negative ANA test.
Clinical correlation is key because it:
- Helps figure out if a positive ANA test is important.
- Can spot false positives.
- Guides what tests to do next.
Follow-Up Testing Options
If an ANA test is positive, more tests are needed to find the cause. These might include blood tests for specific autoantibodies or markers of inflammation.
Some tests we might do next are:
- Extractable nuclear antigen (ENA) panel.
- Rheumatoid factor (RF).
- Complement levels.
By using ANA test results, clinical correlation, and follow-up tests, doctors can make better diagnoses. This helps in creating effective treatment plans.
Conclusion
We’ve looked into how antinuclear antibodies (ANA) help find autoimmune diseases. A positive ANA test might show a health issue. But, we need more tests to know for sure what disease it is.
Knowing what a positive ANA test means is key. The ANA test is helpful but can’t tell us everything. We must look at other signs and tests to find out if a disease is present.
Healthcare experts use ANA tests to guide further checks and treatments. This careful approach helps patients get the right diagnosis and care. A positive ANA test is just the start of figuring out what’s going on.
FAQ
What is an ANA test, and what does it measure?
An ANA test checks for antinuclear antibodies in the blood. These antibodies can show signs of autoimmune diseases.
What are antinuclear antibodies, and how do they affect the body?
Antinuclear antibodies attack the body’s own cells and tissues. This can lead to diseases like lupus or rheumatoid arthritis.
What does a positive ANA test result mean?
A positive test means you have antinuclear antibodies. But it doesn’t mean you definitely have an autoimmune disease.
What is the significance of different ANA patterns, such as speckled or homogeneous?
Different patterns can point to different diseases. For example, a speckled pattern is often linked to lupus or Sjögren’s syndrome.
How are ANA titers measured, and what do they signify?
ANA titers show how much of the antibody is in your blood. Higher titers mean a stronger immune response.
What is the clinical significance of high versus low ANA titers?
High titers suggest a higher risk of autoimmune disease. Low titers might mean you’re healthy or have a milder disease.
How common are positive ANA test results in healthy individuals?
About 3-15% of healthy people can have positive ANA test results. These are usually at low titers.
What factors can lead to false-positive ANA test results?
Age, some medications, or other health issues can cause false-positive results.
What autoimmune conditions are associated with positive ANA test results?
Positive results are linked to diseases like lupus, rheumatoid arthritis, Sjögren’s syndrome, and scleroderma.
Why do only 10-13% of positive ANA tests indicate lupus?
A positive ANA test is just one clue for lupus. Other symptoms and tests are needed to confirm it.
When is an ANA test typically ordered, and what symptoms prompt testing?
Doctors order ANA tests for symptoms like joint pain, skin rashes, or fever. These might suggest an autoimmune disease.
What is the difference between screening and diagnostic ANA testing?
Screening tests look for risk of autoimmune disease. Diagnostic tests confirm or rule out a specific disease.
How is an ANA test performed, and what preparation is required?
ANA tests use a blood sample. Patients might need to fast or avoid certain medications beforehand.
What are the limitations of ANA testing, and why is a positive test not a definitive diagnosis?
A positive ANA test is just one clue. More tests and clinical evaluation are needed to confirm an autoimmune condition.
What follow-up testing options are available after a positive ANA test?
After a positive test, more tests like antibody tests or imaging studies might be needed. They help confirm a diagnosis and guide treatment.
References
National Health Service (NHS). Positive ANA Test: Understanding Antinuclear Antibody Significance. Retrieved from https://www.nhs.uk/conditions/antinuclear-antibody-ana-blood-test/